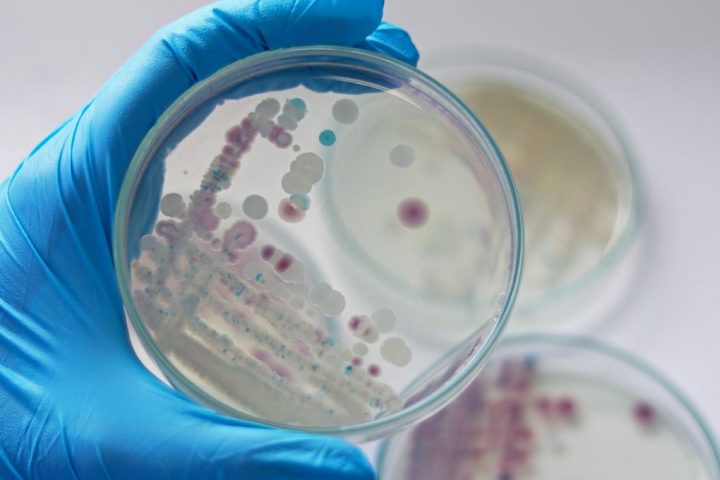

The CDC’s health warning is designed to alert US healthcare providers, laboratories, and public health departments about recent infections by Vibrio vulnificus
A global study looking at cancer diagnoses in the under 50s has found that early onset cancer has increased by 79.1 percent
Two people have been arrested for using machinery to create a gap through a portion of the Great Wall near Youyu in
The Russian space agency Roscosmos estimates that the spacecraft crashed into the Moon after entering an uncontrolled orbit on August 19 at
At its core, the Fermi Paradox grapples with a puzzling contradiction: Considering the enormous size of the universe and the frequent discovery
Photographer Francisco Negroni titled his piece A Perfect Cloud, and we can see why. Lenticular clouds are a rare and striking phenomenon,
Using a new method called FitCoal (fast infinitesimal time coalescent process), the researchers analyzed the likelihood of present-day genome sequences to project
Initial research back in 2016 in the southern Swedish county of Skåne raised alarm bells when it found the incidence of sepsis
The impact was first spotted by the Okinawa-based astronomical observation projects OASES and PONCOTS at 1:45 am Japan Standard Time on August
How our body processes food and generates energy centers around a part of the brain known as the lateral hypothalamic area (LHA),